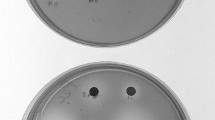

Abstract
Cladosporium parasphaerospermum, Cladosporium chlamydosporigenum, and Cladosporium compactisporum have all been discovered and characterized as new Cladosporium species. The three new species seemed to generate cold-active pectinases with high activity at pH 6.0 and 10 °C, pH 6.0 and 15 °C, and pH 5.0 and 15 °C, respectively, with the most active being C. parasphaerospermum pectinase. In submerged fermentation (SmF), C. parasphaerospermum produced the most cold-active pectinase with the highest activity and specific activity (28.84 U/mL and 3797 U/mg) after 8 days. C. parasphaerospermum cold-active pectinase was isolated using DEAE-Cellulose anion exchange resin and a Sephadex G 100 gel filtration column. The enzyme was purified 214.4-fold and 406.4-fold greater than the fermentation medium using DEAE-cellulose and Sephadex G 100, respectively. At pH 7.0 and 10 °C, pure pectinase had the highest activity (6684 U/mg), with Km and Vmax determined to be 26.625 mg/mL and 312.5 U/min, respectively. At 5 mM/mL, EDTA, MgCl2, and SDS inhibited the activity of pure pectinase by 99.21, 96.03, and 94.45%, respectively. The addition of 10 U/mL pure pectinase enhanced the yield of apple, orange, apricot, and peach juice by 17, 20, 13, and 24%, respectively, and improved the clarity and colour of orange juice by 194 and 339%, respectively. We can now add cold-active pectinase production to the long list of Cladosporium species that have been identified. We also report three new species that can be used in biotechnological solutions as active microbial pectinase producers. Although further research is needed, these distinct species might be used to decompose difficult and resistant pectinacious wastes as well as clear fruit juices.
Similar content being viewed by others
Introduction
Cladosporium is one of the largest and most complex genera of hyphomycetes, which currently includes more than 728 names. Until recently, all types of unrelated dematiaceous hyphomycetes characterized by amero-to-phragmosporous conidia formed in acropetal chains had been referred to Cladosporium1. Species of Cladosporium are well adapted to spread easily in large numbers over long distances, therefore they are cosmopolitan and widely present in all various types of plants and other debris, mostly isolated from air, soil, seeds, grains, food, paint, textiles and other organic matter1,2,3,4,5,6,7,8,9. Several species of this genus are plant pathogenic causing leaf spots and other lesions10, or they occur as hyperparasites on some fungi11.
Cladosporium species are also known to be common endophytes12,13,14 as well as phylloplane fungi15,16,17,18. Some Cladosporium species including C. cladosporioides, C. chlorocephalum and C. uredinicola were recorded as entomopathogens of Aphids and whiteflies19,20. The Genus Cladosporium is considered to be a rich source of diverse and bioactive natural compounds21. Some species were reported to produce anticancer compounds such as L-asparaginase22, paclitaxel23 and useful enzymes including cellulases24 and pectinases25,26,27.
Enzymes are nowadays in great demand in a variety of industrial applications, including food, detergent, paper, textiles, and organic chemical synthesis, due to their high efficiency and environmental friendliness28,29,30. Furthermore, these enzymes are part of a well-established worldwide industry that is expected to grow to US$6.3 billion by few years28,29,30,31. The current tendency is to utilize cold-active enzymes to lower the temperature of industrial processes, allowing for energy savings and reduced carbon footprint, as well as the productive capacity that operate better at ambient or lower temperatures32,33,34. Because they are (i) cost-effective, (ii) energy saving, (iii) capable of catalyzing processes without additional heat aid, and (iv) selectively inactivated by mild heat input35. In biotechnology, cold-active enzymes are used to prevent a range of unwanted reactions and restrict the loss of volatile components36,37,38,39. As a result of these inevitable uses, the function of cold-active enzymes is expected to increase dramatically in the next years39,40.
Pectin is one of the most numerous and complicated polymers that make up the plant cell wall. It is a group of polysaccharides that contain at least seven structural components, the most well-known of which are homogalacturonan, xylogalacturonan, rhamnogalacturonan I, and rhamnogalacturonan II41,42. Pectin is made up of a main chain of galacturonic acid residues bound by (14) links (homogalacturonan), or a mixture of galacturonic acid and rhamnose (rhamnogalacturonans) or galacturonic acid and xylose (rhamnogalacturonans) (xylogalacturonan). Various molecules, such as methyl, ethyl, and various sugar moieties (arabinose, rhamnose, galactose, and others), can then be replaced for the main chain43. Pectin biodegradation necessitates the coordinated activity of multiple enzymes known collectively as pectinases, due to its complicated structure. Pectin methyl esterases, pectin acetyl esterases, polygalacturonases, polymethylgalacturonases, polygalacturonate lyases, polymethylgalacturonate lyases, rhamnogalacturonase, arabinases, and xylogalacturonases are all examples of pectinases42.
Around 10% of the enzyme market is made up of pectinolytic enzymes, which are used in the juice, food, paper, and textile industries44,45,46. Low temperatures (15 °C) are employed in the juice industry to minimize cloudiness and bitterness in fruit juices in order to prevent the spread of harmful bacteria, preserve labile and volatile flavor components, and save energy34,45. Researchers have been looking for pectinases that can act at low temperatures but also at low pH, because the pH of fruit juices and grape must be between 2.5 and 3.542. Pectinases are presently derived from mesophilic filamentous fungi, mostly Aspergillus species, however they work poorly below 35 °C47. Cold-active enzymes, on the other hand, have higher enzymatic activity than mesophilic enzymes at lower temperatures48. As a result, the current research sought to develop cold-active pectinases from three newly-discovered Cladosporium species from Egypt, as well as purify, characterize, and use the most active pectinase in fruit juice production.
Results
Molecular studies
Cladosporium parasphaerospermum AUMC 10865
ITS: Based on a megablast search of NCBIs GenBank nucleotide database, the closest hits using ITS sequence are Cladosporium cladosporioides, Cladosporium parahalotolerans and Cladosporium halotolerans [(GenBank KJ767065, MK262909 and MK258720; identities = 554/556 (99.64%); Gaps = 1/556 (0%)]. ACT: the closest hits using ACT sequence are Cladosporium halotolerans and Cladosporium omanense [(GenBank MF084398 and MH716046; identities 127/132 (96.21%); Gaps = 1/132 (0%)]. LSU: the closest matches using LSU are Digitaria exilis [(GenBank LR792838; identities = 1142/1152 (99.13%); Gaps = 10/1152 (0%)] and Cladosporium delicatulum [(GenBank JQ732984 and JQ732983; identities = 1140/1152 (98.96%); Gaps = 10/1152 (0%)].
Cladosporium chlamydosporigenum AUMC 11340
ITS: Based on a megablast search of NCBIs GenBank nucleotide database, the closest hits using ITS sequence are Cladosporium subcinereum [(GenBank OK510262; identities = 551/554 (99.46%); Gaps = 2/554 (0%)] and Cladosporium floccosum [(GenBank MK460809; identities = 549/553 (99.28%); Gaps = 3/553 (0%)]. ACT: the closest hits using ACT sequence are Davidiella tassiana [(GenBank EU730605; identities = 229/230 (99.57%); Gaps = 0/230 (0%)] and Cladosporium herbarum [(GenBank EF679510 and EF679511; identities = 228/230 (99.13%) and 227/230 (98.70%); 0/230 (0%)]. While compared to the type materials, the closest hits are Cladosporium macrocarpum [(GenBank EF679529; identities = 226/230 (98.26%); Gaps = 0/230 (0%)], Cladosporium herbarum [(GenBank EF679516; identities = 225/230 (97.83%); Gaps = 0/230 (0%)] and Cladosporium versiforme [(GenBank KT600613; identities = 216/227 (95.15%); Gaps = 3/227 (1%)]. LSU: the closest hits using LSU sequences are Cladosporium herbarum and Cladosporium allicinum [(GenBank MH047193 and GU214408; identities = 1184/1199 (98.75%); Gaps = 13/1199 (1%)].
Cladosporium compactisporum AUMC 11366
ITS: Based on a megablast search of NCBIs GenBank nucleotide database, the closest hits using ITS sequence are Cladosporium cladosporioides [(GenBank ON045558 and MT367253; identities = 547/552 (99.09%) and 548/554 (98.92%); Gaps = 0/552 (0%) and 1/554 (0%)]. ACT: the closest hits using ACT sequence are Cladosporium cladosporioides [(GenBank KY886457; identities = 232/232 (100%); Gaps = 0/232 (0%)], Cladosporium proteacearum (ex-type) [(GenBank MZ344213; identities = 223/229 (97.38%); Gaps = 0/229 (0%)], Cladosporium devikae (ex-type) [(GenBank MZ344212; identities = 212/216 (98.15%); Gaps = 1/216 (0%)] and Cladosporium cladosporioides (ex-type) [(GenBank HM148490; identities = 220/230 (95.65%); Gaps = 0/230 (0%)]. LSU: the closest hits using LSU sequence are Cladosporium delicatulum and Cladosporium uredinicola [(GenBank JQ732985 and EU019264; identities = 1206/1221 (98.77%); Gaps = 12/1221 (0%)], Toxicocladosporium irritans (ex-type) [(GenBank EU040243; identities = 1184/1221 (96.97%); Gaps = 12/1221 (0%)], and Rachicladosporium inconspicuum (type) [(NG_059443; identities = 1159/1224 (94.69%); Gaps = 16/1224 (1%)].
Phylogenetic analyses
Descriptive statistical parameters of phylogenetic analyses and calculated tree scores for each analyzed sequence locus are summarized in Table 1. The constructed phylogenetic trees for ITS, ACT and LSU are shown in Figs. 1, 2, 3, respectively.
Taxonomy
Cladosporium parasphaerospermum sp. nov
Moharram AM, Zohri AA, Hesham A, Maher MA and Al-Bedak OA.
MycoBank
MB 844532.
Etymology
Name refers to globose to subglobose conidia near to that of C. sphaerospermum.
Holotype
Egypt, Beni Suef, Air, Maher MA, AUMC 10865. Ex-type culture: EMCCN: 2062.
Macroscopic and microscopic characteristics
Colonies on PDA reaching 18–20 mm diameter after 7 days at 28 °C, raised at the center, radially sulcate, radially furrowed under the colony, olive, olive green at the center (2F6). Margin curled, paler than the colony center (3F8). Sporulation profuse. Exudates absent. Colonies on SNA reaching 17–19 mm in diameter after 7 days at 28 °C, flat, slightly raised at the center, circular, olive, olive green (3F4-6). Margin entire. Sporulation abundant. Exudates absent. On OA colonies attaining 16–19 mm in diameter after 7 days at 28 °C, circular, flat, somewhat lanuginose, dark olive, dark olive green (1F4-6). Margin entire. Sporulation abundant. Exudates absent. Mycelium abundantly formed, branched, 3–5 µm wide, septate, pale brown to brown, smooth. Conidiophores macronematous, micronematous, abundantly formed, arising terminally or laterally, more or less straight to flexuous, cylindrical, pale brown to brown, smooth, septate, commonly (− 35) 75–100 × 3–5 µm (av. 87.5 × 4) µm (n = 50), not constricted at septa. Ramoconidia integrated, terminal, intercalary, cylindrical, smooth, thick-walled, 0–1 septate, 8–18 × 3–5 µm (av. 13 × 4) µm (n = 50), with 1–3 loci per cell. Loci usually confined to small lateral shoulders, protuberant, conspicuous, short cylindrical, 1–2 µm wide, up to 1–2 µm high. Conidia brown to dark brown, smooth, thick-walled, globose, subglobose, lemon-shaped, 0–septate, 4–6 × 3–5 µm (av. 5 × 4) µm (n = 50). Chlamydospores not formed (Fig. 4).
Maximum likelihood phylogenetic tree generated from ML/MP combination analysis based on alignment of ITS sequences of C. parasphaerospermum AUMC 10865, C. chlamydosporigenum AUMC 11340 and C. compactisporum AUMC 11366 with the most similar sequences belonging to Cladosporium in GenBank database. Sequences of species in this study are in blue color. Bootstrap support values (1000 replications) for ML/MP combination equal to or greater than 50% are indicated at the respective nodes. The tree was rooted to sequence of Cercospora beticola CBS 116456 as outgroup (in red color).
Maximum likelihood phylogenetic tree generated from ML/MP combination analysis based on alignment of ACT sequences of C. parasphaerospermum AUMC 10865, C. chlamydosporigenum AUMC 11340 and C. compactisporum AUMC 11366 with the most similar sequences belonging to Cladosporium in GenBank database. Sequences of species in this study are in blue color. Bootstrap support values (1000 replications) for ML/MP combination equal to or greater than 50% are indicated at the respective nodes. The tree was rooted to sequence of Cercospora beticola CBS 116456 as outgroup (in red color).
Maximum likelihood phylogenetic tree generated from ML/MP combination analysis based on alignment of LSU sequences of C. parasphaerospermum AUMC 10865, C. chlamydosporigenum AUMC 11340 and C. compactisporum AUMC 11366 with the most similar sequences belonging to Cladosporium in GenBank database. Sequences of species in this study are in blue color. Bootstrap support values (1000 replications) for ML/MP combination equal to or greater than 50% are indicated at the respective nodes. The tree was rooted to sequence of Cercospora beticola CBS 116456 as outgroup (in red color).
Cladosporium chlamydosporigenum sp. nov
Moharram AM, Zohri AA, Hesham A, Maher MA and Al-Bedak OA.
MycoBank
MB 844533.
Etymology
Refers to the formation of chlamydospores in culture.
Holotype
Egypt, Sohag, Grapevine fruits, Maher MA, AUMC 11340. Ex-type culture: EMCCN: 2332.
Macroscopic and microscopic characteristics
Colonies on PDA reaching 15–17 mm diameter after 7 days at 28 °C, raised at the center, wrinkled, irregular, olive, olive green (3F6-7). Margin undulate, narrow, paler than the center (3E5-6). Sporulation abundant. Exudates absent. On SNA colonies attaining 9–11 mm in diameter after 7 days at 28 °C, flat, filamentous, olive, olive green (3E2). Margin filiform, narrow, (3E6-7). µm (av. 250 × 5) µm (n = 50), not constricted at septa. Ramoconidia integrated, terminal, intercalary, cylindrical, 11–22 × 6–8 µm (av. 16.5 × 7) µm (n = 50), verruculose to finely roughened, 0–2 septa with 1–3 loci per cell, Loci usually confined to small lateral shoulders, protuberant, conspicuous, short cylindrical, 1–2 µm wide, up to 1 µm high. Conidial chains unbranched or branched, conidia pale brown, straight, subglobose, obovoid to ellipsoid, verruculose to finely roughened, 0–septate, 4–11 × 5–7 µm (av. 7.5 × 6) µm (n = 50). Chlamydospores produced in hyphae, intercalary, aggregated, brown to dark brown, thick-walled, globose, subglobose, 15–25 × µm (Fig. 5).
Cladosporium compactisporum sp. nov
Moharram AM, Zohri AA, Hesham A, Maher MA and Al-Bedak OA.
MycoBank
MB 844534.
Etymology
Refers to the compact conidial chains.
Holotype
Egypt, Qena, Air, Maher MA, AUMC 11366. Ex-type culture: EMCCN: 2358.
Macroscopic and microscopic characteristics
Colonies on PDA attaining 25–28 mm after 7 days at 28 °C, raised, umbonate, circular, olive to olive green (3E3-3F4). Margin entire, narrow, about 3.0 mm in width, paler than the colony center (3E1-3). Sporulation profuse. Exudates absent. Colonies on SNA attaining 17–20 mm diameter after 7 days at 28 °C, raised, umbonate, olive to olive green (3F6-7). Margin entire, about 3.0 mm in width, paler than the colony center (3E2-3). Sporulation abundant. Exudates absent. Colonies on OA attaining 19–23 mm in diameter after 7 days at 28 °C, raised, umbonate, lanuginose, olive grey (2E1-2). Margin undulate, narrow, dark olive grey (2F2). Sporulation abundant. Exudates lacking. Mycelium abundantly formed, branched, 3–5 µm wide, septate, swollen, pale brown to brown, smooth. Conidiophores macronematous and micronematous, abundantly formed, arising terminally or laterally, more or less straight to flexuous, nodulose, geniculate at the upper part, cylindrical, pale brown to brown, smooth, septate, branched, 100–300 µm × 3.0–6.0 µm (av. 200 × 4.5) µm (n = 50). Ramoconidia integrated, terminal, intercalary, cylindrical, 7–22 × 3–4 µm (av. 14.5 × 3.5) µm (n = 50), smooth, 0–1 septa with 1–3 loci per cell. Loci usually confined to small lateral shoulders, protuberant, conspicuous, short cylindrical, 1 µm wide, up to 1–2 µm high. Conidia formed in compact and branched chains, pale brown, subglobose, obovoid to ellipsoid, smooth, 0-septate, 4–6 × 3–4 µm (av. 5 × 3.5) µm (n = 50). Chlamydospores not formed (Fig. 6).
Optimization of cold-active pectinases production by the three Cladosporium strains
Effect of pH and temperature on pectinase production
Cladosporium parasphaerospermum AUMC 10865, Cladosporium chlamydosporigenum AUMC 11340, and Cladosporium compactisporum AUMC 11366 cold-active pectinase production was investigated in this work by altering the pH of the fermentation medium between pH 3.0 and 10.0 each at 5°, 10°, and 15°. Cladosporium parasphaerospermum AUMC 10865 produced the most pectinase (26.3 ± 2.1 U/mL) at pH 6.0 and 10 °C (Fig. 7), whereas C. chlamydosporigenum AUMC 11340 produced the most (24.63 ± 2.5 U/mL) at pH 6.0 and 15 °C (Fig. 8), and C. compactisporum AUMC 11366 (21.93 ± 2.3 U/mL) at pH 5.0 and 15 °C (Fig. 9).
Effect of nitrogen source and incubation time
Pectinase production by Cladosporium parasphaerospermum AUMC 10865 was enhanced (28.84 ± 2.7 U/mL) after 8 days incubation using sodium nitrate as a nitrogen source (Fig. 10). While, ammonium chloride was found to be best for pectinase production by Cladosporium chlamydosporigenum AUMC 11340 (26.6 ± 1.28 U/mL), and Cladosporium compactisporum AUMC 11366 (24.01 ± 1.76 U/mL) after 9 days (Figs. 11, 12).
Production of cold-active pectinase by C. parasphaerospermum AUMC 10865 in SmF
In submerged fermentation at the optimum conditions, the three fungi produced pectinases at a rather high output. Cladosporium parasphaerospermum generated 5.6 g of pectinase powder per liter of fermentation media, followed by C. chlamydosporigenum at 3.65 g and C. compactisporum at 2.85 g (Fig. 13). For purification and use, the C. parasphaerospermum AUMC 10865 pectinase that was the most cold-active was chosen.
Purification of pectinase produced by Cladosporium parasphaerospermum AUMC 10865
The Cladosporium parasphaerospermum AUMC 10865 pectinase was homogenized using a number of techniques. Initial partial purification of the enzyme involved adding solid ammonium sulphate to the cell-free supernatant. The fraction with a salt saturation of 70% showed pectinase activity. This fraction was dialyzed with citrate buffer (pH 6.0) and freeze-dried before being applied to the anion exchanger (DEAE-Cellulose), which was pre-equilibrated with 50 mM citrate buffer (pH 6.0). The proteins were extracted using a gradient of NaCl (0–1.5 M).
Purification profile of pure pectinase
Pectinase activity was discovered in fractions 60–150 of a DEAE-Cellulose column (Fig. 14), which were pooled, concentrated, and dialyzed against citrate buffer (pH 6.0). This cycle of purification increased pectinase purity by 214.4-fold, with a specific activity of 1005.55 U/mg protein (Table 2). The fractions with the highest pectinase activity were pooled, condensed with a freeze drier, and loaded onto a Sephadex G-100 column (Fig. 15). The pectinase activity-highest fractions were pooled, concentrated, and dialyzed against citrate buffer (pH 6.0). With a specific activity of 1906 ± 65 U/mg protein, this phase of purification resulted in a 406.4-fold improvement in pectinase purity (Table 2).
Effect of pH and temperature on the pure pectinase activity
The activity of pure pectinase was further tested in the presence of various physical and chemical factors. The purified pectinase has an optimal pH of 7.0. The purified pectinase had the highest activity (4553 ± 124 U/mg) at pH 7.0 and 5 °C, which increased to 6684 ± 173 U/mg at 10 °C (Fig. 16).
Effect of some ions and inhibitors on the pure pectinase activity
The purified enzyme was sensitive to all salts tested at a concentration of 5 mmol/mL. Pectinase activity was significantly reduced by 99.21, 96.03, and 94.45% using EDTA, MgCl2, and SDS, respectively in the reaction (Table 3).
Kinetic constants of the pure pectinase
The current findings revealed that Michaelis–Menten constant (Km) and the maximum reaction velocity (Vmax) values for the pure pectinase were calculated as 26.625 mg/mL and 312.5 U/min (Fig. 17).
Fruit juice production by the pure pectinase
When compared to the control, the enzyme treatment for all of the fruit pulp used resulted in a significant improvement in juice yield, clarity, and colour. It was determined how enzyme treatments affect the extraction of apple, orange, apricot, and peach juices. Enzyme addition increased juice recovery in all fruits. The enzyme treatment of apple, orange, apricot, and peach resulted in a significant increase in juice yield of 16.45, 16.43, 15.93, and 8.73%, respectively. The results also revealed a significant improvement in the clarity and colour of the juice derived from the pulp of the orange fruit, reaching 194.0% and 338.6%, respectively, above the control, while the rest of the fruits employed showed just a modest rise (Table 4).
Discussion
Identification of novel species is at the heart of biodiversity research, and in recent years biodiversity efforts have been favouring DNA based method to morphology-based ones49,50,51,52,53. Understanding of the microbial composition aids awareness of host–microbe interactions and their environmental function, revealing a complex and delicate balance that can be easily upset54,55,56. Due to the complexity of fungal genomes and the lack of verified databases documenting appropriate biodiversity, such metagenomic studies in fungi are still limited. Identification of novel species is crucial in biodiversity research, which has lately adopted DNA-based methodologies. In this work, we introduced three new Cladosporium species as Cladosporium parasphaerospermum, Cladosporium chlamydosporigenum, and Cladosporium compactisporum based on the morphological characteristics as well as phylogenetic analyses of ITS, ACT, and LSU loci.
Cladosporium parasphaerospermum, C. chlamydosporigenum, and C. compactisporum species clades were supported by ITS rDNA and partial actin gene analyses, with C. parasphaerospermum and C. compactisporum separated in the ACT tree each by a single long branch, and C. chlamydosporigenum separated by a single short branch. Because the three strains occupied discrete lineages, the LSU tree validated their uniqueness. C. parasphaerospermum can be recognized from C. halotolerans57, and C. parahalotolerans57 by its smaller ramoconidia (8–18 µm), which measure 15–37 and 24–37 µm, in both species, respectively. C. chlamydosporigenum is distinguished from other Cladosporium species in ITS clade by smaller conidia (4–11 µm) and ramoconidia (11–22 µm), as well as the formation of chlamydospores and the absence of head-like swellings with additional intercalary swellings. C. compactisporum was discovered in ITS tree as part of a moderately supported clade alongside C. cladosporioides and C. tenuissimum, and in the ACT tree as part of the C. salinae clade on a lengthy distinct branch. It produces smaller ramoconidia (7–22 µm) with 1–3 loci than C. cladosporioides (15–50 µm), which has up to 4 loci packed at the tip. C. compactisporum differs from C. tenuissimum57 in that it has geniculate and nodulose conidiophores with compact conidial chains, whereas most C. tenuissimum conidiophores are neither geniculate nor nodulose. On Oat agar, C. tenuissimum has a longer conidiophore (up to 900 µm) than C. compactisporum. Conidiophores of 100–300 × 3–6 µm in length and ramoconidia of 7–22 µm in length distinguish C. compactisporum from C. salinae58, which has weakly differentiated conidiophores (25–50 × 2.5–3 µm) and smaller ramoconidia (9.5–13.5 × 2.5–3.5 µm).
The current research aimed to isolate cold-active pectinases from three novel Cladosporium species that could function at low temperatures. The three strains produced a considerable amount of cold-active pectinases, which were active at temperatures as low as 5 and 10 °C. This is the first report of cold-active pectinase production from psychrotolerant Cladosporium species that we are aware of.
Pectinase has lengthy been used in commercial food processing to degrade pectin and aid in various processing steps such as liquefaction, clarification, and juice extraction59. Pectinases are among the most widely used enzymes, accounting for 40% of all food enzymes44,60. It has been demonstrated that certain Cladosporium species generate active pectinases9,25,26,61,62,63. However, the synthesis, optimization, purification, and application of a cold-active pectinase in this study is groundbreaking. Due to minor changes in methodology, it is difficult to compare the values of enzyme activity reported by different researches. As a result, comparisons should be made with care.
Because of their biodegradability, non-toxicity, high selectivity, and high yields, microbial enzymes are superior to chemical synthesis64. The global enzyme market was valued at $9.9 billion in 2019 and is expected to grow at a 7.1% annual rate from 2020 to 202765. The majority of commercial enzymes, including pectinase, are now mesophilic or thermophilic. In the food sector, and particularly in the fruit processing sector, there has been an increasing desire to replace high-temperature procedures with low-temperature processes. Specific economic and environmental benefits, such as energy savings, retention of biologically inert and aromatic fragrance components, contamination mitigation, and eradication of any residual enzyme activity, which cause deactivation of enzyme when temperature is raised, are driving this shift in trend34,59,65,66,67.
Pectinases released by microorganisms account for approximately 25% of global food enzyme sales. The vast majority of which is derived from filamentous fungi, specifically Aspergillus niger68,69. It is uncommon for filamentous fungi to produce pectinase activity below 40 °C. This is true even for filamentous fungi that are psychrophilic or psychrotolerant. Sclerotinia borealis, a pathogenic fungus prevalent in extremely cold locations that does not grow over 20 °C, generates pectinases with optimal activity at 40 °C70. Mucor flavus is another example of a psychrotolerant fungus that generates pectinases with optimum activity at 45 °C71.
To the best of our knowledge, there is just one case of a filamentous fungus generating pectinases with optimal activity below 40 °C in the literature. Botrytis cinerea, a phytopathogenic fungus, generates pectinases with optimum activity between 34 and 37 °C72. In this investigation, Cladosporium parasphaerospermum produced high quantity of pectinase with the maximum activity at pH 7.0 and 10 °C. Thus, this is the first study to purify and exploit cold-active pectinase from Cladosporium species, which might be great candidates for cold-active enzyme synthesis. Industrial pectinases generated from fungi are a blend of pectinolytic enzymes and other proteins. Other commercial processes, such as fruit juice clarity, require only one kind of pectinase activity. As a result, other sources of pectinase must be investigated. The catalytic properties and stability of an enzyme in diverse physio-chemical conditions are important for commercialization.
Pectinase activity in a pure preparation of Cladosporium parasphaerospermum was described and evaluated in this work for its potential application in fruit juice clearing. The use of Cladosporium parasphaerospermum pure pectinase improved juice recovery in all fruits used. The enzyme treatment of apple, orange, apricot, and peach resulted in a considerable increase in juice output. The results also demonstrated a considerable improvement in the purity and colour of the juice obtained from orange fruit.
Conclusion
In the current study, three novel Cladosporium species were introduced and described as Cladosporium parasphaerospermum, C. chlamydosporigenum, and C. compactisporum. The three novel species appeared to produce cold-active pectinases that had high activity at pH 6.0 and 10 °C, pH 6.0 and 15 °C, and pH 5.0 and 15 °C, respectively, of which C. parasphaerospermum pectinase was the most active. The enzyme was purified by 214.4-fold and 406.4-fold by DEAE-Cellulose and Sephadex G 100, respectively. The highest activity of the pure pectinase was gained at pH 7.0 and 10 °C. Km and Vmax were calculated to be 26.625 mg/mL and 312.5 U/min, respectively. The use of pure pectinase boosted the yield of apple, orange, apricot, and peach juice and improved the clarity and colour of orange juice. We can now add cold-active pectinase production to the long list of Cladosporium species that have been identified. We also report three new species that can be used in biotechnological solutions as active microbial pectinase producers. Although further research is needed, these distinct species might be used to decompose difficult and resistant pectinacious wastes as well as clear fruit juices.
Materials and methods
Isolation and maintenance of Cladosporium strains
Three Cladosporium isolates involved in the current study, of which two were isolated from air of Beni Suef and Qena cities and one from fruits of grapevine cultivated in Sohag city, Egypt. Settle plate method73 was employed for isolation of Cladosporium from air and direct plating technique74 for isolation from grapevine fruits. Czapek’s Dox agar was used as an isolation medium. The isolation medium contained (g/L): Sucrose, 30; Na2NO3, 2; K2HPO4, 1; KCl, 0.5; MgSO4.7H2O, 0.5; FeSO4, 0.01; ZnSO4, 0.01; CuSO4, 0.005; Rose Bengal, 0.05; chloramphenicol, 0.25; agar, 15 and the final pH 7.3. The newly discovered strains were preserved as frozen and lyophilized cultures and added to the culture collections of the Assiut University Mycological Centre (AUMC) and the Egyptian Microbial Culture Collection Network (EMCCN) as AUMC 10865 = EMCCN 2062 (Air, Beni Suef, Egypt), AUMC 11340 = EMCCN 2332 (Grapevine fruits, Sohag, Egypt), and AUMC 11366 = EMCCN 2358 (Air, Qena, Egypt). The new species were catalogued in the MycoBank with accession numbers MB844532, MB844533, and MB844534, respectively, along with their descriptions. Nexus file of the sequence alignments for all data sets were uploaded to Tree BASE http://purl.org/phylo/treebase/phylows/study/TB2:S30171?x-access-code=a18696d1afcf659925a63a31c3ebd045&format=html (Study no. 30171).
Morphological studies of the Cladosporium strains
For growth rate determination and phenetic description of colonies, strains were point inoculated on potato dextrose agar (PDA), synthetic nutrient agar (SNA) and oat meal agar (OA)75,76, and incubated at 25 °C for 14 days in darkness. Surface colours were rated using the colour charts77.
Molecular identification of the Cladosporium strains
DNA extraction, PCR and sequencing of ITS, ACT and LSU
DNA isolation of Cladosporium isolates AUMC 10865, AUMC 11340 and AUMC 11366 was performed following CTAB method78. The universal primers ITS1 and ITS479 were used for amplification of the internal transcribed spacer (ITS) region, ACT783R and ACT512F for amplification of ACT gene80, and LROR and LR781 for amplification of the large subunit (LSU). PCR was done following Al-Bedak and Moubasher82.
Alignments and phylogenetic analyses
Sequences of Cladosporium species (ITS, ACT, LSU) in this study were compared to the type and ex-type species in GenBank. MAFFT (version 6.861b) with the default options83 was used for alignment of the three sequence sets (ITS, ACT, LSU) in this study. Cercospora beticola CBS 116456 was used as outgroup. Alignment gaps and parsimony uninformative characters were optimized by BMGE84. Maximum-likelihood (ML) and Maximum parsimony (MP) phylogenetic analyses were performed using PhyML 3.085. The robustness of the most parsimonious trees was evaluated by 1000 replications86. The best optimal model of nucleotide substitution for the ML analyses was determined using Akaike Information Criterion (AIC) as implemented in Modeltest 3.787. The phylogenetic tree was drawn and visualized using MEGA X 10.2.688,89. The resulting tree was edited using Microsoft Power Point (2016) and saved as TIF format9.
Optimization of cold-active pectinase production by the Cladosporium strains
In a previous study, the three Cladosporium strains (AUMC 10865, AUMC 11340 and AUMC 11366) were found to be capable of producing cold-active pectinases in SmF at 10 °C27. For maximization of pectinase production, pH, temperature, nitrogen source and fermentation time influencing pectinase production were optimized by varying parameters using two factors at a time (TFAT) for the three strains. The experiments were conducted in 250 mL Erlenmeyer flasks each with 50 mL fermentation medium (sucrose-free Czapek’s broth) supplemented with 1% citrus pectin as a sole carbon source. The flasks were inoculated separately with spore suspension (1%; v/v) obtained from 7-day-old of Cladosporium strains, and incubated under different operating conditions such as pH (3.0, 4.0, 5.0, 6.0, 7.0, 8.0, 9.0, and 10.0), each at 5, 10, and 15 °C, and nitrogen source (peptone, yeast extract, sodium nitrate, ammonium sulfate, and ammonium chloride; each at 0.2%), at 1–10 days of incubation. Three replications of the experiment were performed.
Pectinase assay
The colorimetric approach was used to measure pectinase activity90. Under static circumstances, 0.5 mL of adequately diluted cell-free supernatant was incubated with 0.5 mL of 1.0% citrus pectin (prepared in 50 mM Na-citrate buffer, pH 6.0) for 20 min at 10 °C. The mixture was boiled for 15 min after 2.0 mL of 3, 5-Dinitrosalicylic acid (DNS) was added. The colour created was evaluated at 540 nm for absorption. The quantity of enzyme that catalyses the synthesis of 1 µmol of galacturonic acid per minute at the standard assay conditions was defined as one unit of pectinase.
Production of cold-active pectinase by Cladosporium parasphaerospermum in SmF
For pectinases production by Cladosporium parasphaerospermum AUMC 10865, the fungus was employed in Erlenmeyer flasks (500 mL) in SmF at the optimum conditions using the fermentation medium. Cladosporium species was inoculated with 1.5 × 108 spore/mL spore suspensions obtained from 7-day-old cultures. The incubation period lasted at 10 °C and 150 rpm.
Purification of the cold-active pectinase
Ammonium sulfate precipitation and dialysis
Following the incubation time, cell-free supernatant was recovered by centrifuging at 10,000 rpm for 10 min. At 4 °C, total protein was isolated using 70% saturated solution of ammonium sulphate. A freeze dryer (VirTis, model #6KBTES-55, NY, USA) was used to separate and lyophilize the precipitated protein. Lyophilized protein was dissolved in citrate buffer (pH 6.0) and dialyzed twice for 2 h at room temperature (cutoffs: 12–14 KD) against deionized water, eliminating the water each time, before being refrigerated overnight at 4 °C to remove salts and small molecules. The dialyzed protein was then lyophilized, and used in enzyme characterization experiments as partially purified fungal pectinase.
Ion exchange chromatography
A glass column (30 × 2.0 cm; 75 cm3 bed volume) was filled with DEAE-Cellulose anion exchanger. After equilibrating the column with citrate buffer (50 mM, pH 6.0), a 6.0 mL sample was loaded onto it. With NaCl concentrations of 0, 0.1, 0.25, 0.5, 1.0, and 1.5 M, the enzyme was eluted with citrate buffer. The volume of the fractions was 5.0 mL. The pectinase activity was assessed using the previous approach. The fractions with the highest pectinase activity were mixed, concentrated, and kept for further study.
Gel filtration chromatography
In a glass column, Sephadex G 100 was packaged (55 × 2.5 cm; bed capacity 270 cm3). The protein was eluted using citrate buffer (50 mM, pH 6.0) after this column was loaded with the concentrated sample (15 mL). Pectinase activity were evaluated using the techniques described previously in fractions of 5.0 mL volume. The pectinase-positive portions were mixed together, concentrated, and kept for future research.
Impact of pH, temperature and some ions and inhibitors on the pure pectinase activity
The impact of pH (3.0–10.0) at 5–15 °C on pure pectinase activity was investigated. The reaction mixture contained 100 µL pure enzyme and 900 µL pectin (dissolved in 50 mM buffer solution). After the reaction time (20 min), the reaction was terminated by introducing 2.0 mL of 3,5-dinitrosalicylic acid (DNS)90, and the pectinase activity was determined as previously mentioned. The buffers used were citrate buffer (pH 3.0–6.0), phosphate buffer (pH 7.0–8.0), and glycine/NaOH buffer (pH 9.0–10.0). Also, some ions (Na+, K+, Ca+2, Co+2, Ni+2, Cu+2, Fe+2, Mg+2, Mn+2, and Zn+2) were evaluated by introducing them at 5 mM/mL concentrations as NaCl, KCl, CaCl2, CoCl2, NiSO4, CuSO4, FeSO4, MgSO4, MnSO4, and ZnSO4. A 5 mM/mL ethylenediaminetetraacetic acid (EDTA) and sodium dodecyl sulfate (SDS) were also used to evaluate an enzyme inhibitor. Under standard conditions, the activity of the microbial pectinase in the absence of metal ions or EDTA or SDS was evaluated to define 100% activity. Three replications of the experiment were performed.
Determination of kinetic constant (Km and Vmax)
Km (Michaelis–Menten constant) and Vmax (maximum reaction velocity) values of the purified pectinase were determined by measuring enzyme activity at different concentrations of citrus pectin (1–16 mg/mL), using the Line-weaver-Burk equation91.
Application of the pure pectinase in fruit juice production
Apple, orange, apricot, and peach pulps were examined for juice production, clarity, colour, and pH using Cladosporium parasphaerospermum AUMC 10865’s pure pectinase. Each fruit pulp was treated with 10 U/mL pectinase enzyme (v/v), with untreated fruit pulps serving as controls. The processed fruit pulps were then incubated at 10 °C for 60 min. After inactivating the enzyme by boiling for 5 min, samples were recovered by centrifugation at 5000×g for 10 min. for clarity measurements. The juice yield was estimated by dividing the juice mass by the fruit mass92.
Statistical analysis
Data were subjected to analysis of variance (ANOVA: two-factor with replication) followed by the Duncan’s multiple range test93.
Data availability
The newly discovered strains were preserved as frozen and lyophilized cultures and added to the culture collections of the Assiut University Mycological Centre (AUMC) and the Egyptian Microbial Culture Collection Network (EMCCN) as AUMC 10865 = EMCCN 2062 (Air, Beni Suef, Egypt), AUMC 11340 = EMCCN 2332 (Grapevine fruits, Sohag, Egypt), and AUMC 11366 = EMCCN 2358 (Air, Qena, Egypt). The new species were catalogued in the MycoBank with accession numbers MB844532 (MycoBank Typification; MBT 10007647), MB844533 (MycoBank Typification; MBT 10007648), and MB844534 (MycoBank Typification; MBT 10007649), respectively, along with their descriptions. Nexus file of the sequence alignments for all data sets were uploaded to Tree BASE http://purl.org/phylo/treebase/phylows/study/TB2:S30171?x-access-code=a18696d1afcf659925a63a31c3ebd045&format=html (Study no. 30171). The datasets generated and/or analyzed during the current study are available in the GenBank repository (https://www.ncbi.nlm.nih.gov/genbank) and MycoBank (https://www.mycobank.org/).
Change history
22 September 2023
A Correction to this paper has been published: https://doi.org/10.1038/s41598-023-42490-7
References
Bensch, K., Braun, U., Groenewald, J. Z. & Crous, P. W. The genus Cladosporium. Stud. Mycol. 72, 1–401 (2012).
Ellis, M. More Dematiaceous Hyphomycetes 507 (Commonwealth Mycological Institute, 1976).
Yehia, R. S., Osman, G. H., Assaggaf, H., Salem, R. & Mohamed, M. S. Isolation of potential antimicrobial metabolites from endophytic fungus Cladosporium cladosporioides from endemic plant Zygophyllum mandavillei. S. Afr. J. Bot. 134, 296 (2020).
Moubasher, A. H. Soil Fungi in Qatar and Other Arab Countries (University of Qatar, 1993).
Ismail, M. A., Moubasher, A. H., Mohamed, R. A. & Al-Bedak, O. A. Extremophilic fungi and chemical analysis of hypersaline, alkaline lakes of Wadi-El-Natrun, Egypt. Int. J. Tech. Res. Sci. 1, 345–363 (2017).
Farr, D. F., Bills, G. F., Chamuris, G. P. & Rossman, A. Y. Fungi on Plants and Plant Products in the United States (APS Press, 1989).
Haas, C. N. Microorganisms in home and indoor work environments: Diversity, health impacts, investigation and control edited by Brian Flannigan, Robert A. Samson, and J. David Miller. Risk Anal. 31, 1327–1327 (2011).
Flannigan, B., Samson, R. A. & Miller, J. D. Microorganisms in Home and Indoor Work Environments: Diversity, Health Impacts, Investigation and Control (CRC Press, 2016).
Al-Bedak, O. A. et al. Impact of fumigation with phosphine on viability of wheat grains stored for six months at two levels of moisture content, in addition to description of four new records of associated fungi and assessment of their potential for enzymatic production. J. Basic Appl. Mycol. (Egypt) 11, 77–97 (2020).
Schubert, K. & Braun, U. Taxonomic revision of the genus Cladosporium s. lat. 2. Cladosporium species occurring on hosts of the families Bignoniaceae and Orchidaceae. Sydowia 56, 296–317 (2004).
Heuchert, B., Braun, U. & Schubert, K. Morphotaxonomic revision of fungicolous Cladosporium species (hyphomycetes). Schlechtendalia 13, 1–78 (2005).
Riesen, T. & Sieber, T. Endophytic Fungi in Winter Wheat (Titicum aestivum L.) 190 (Swiss Federal Institute of Technology, 1985).
Brown, K. Preliminary studies on endophytic fungal communities of Musa acuminata species complex in Hong Kong and Australia. Fung. Divers. 1, 27–51 (1998).
El-Morsy, E. Fungi isolated from the endorhizosphere of halophytic plants from the Red Sea Coast of Egypt. Fung. Divers. 5, 43–54 (2000).
Islam, M. & Hasin, F. Studies on the phylloplane mycoflora of Amaranthus viridis L.. Nat. Acad. Sci. Lett. 23, 121–123 (2000).
Inácio, J. et al. Estimation and diversity of phylloplane mycobiota on selected plants in a mediterranean-type ecosystem in Portugal. Microb. Ecol. 44, 344–353 (2002).
Stohr, S. & Dighton, J. Effects of species diversity on establishment and coexistence: A phylloplane fungal community model system. Microb. Ecol. 48, 431–438 (2004).
Levetin, E. & Dorsey, K. Contribution of leaf surface fungi to the air spora. Aerobiologia 22, 3–12 (2006).
Abdel-Baky, N., Arafat, N. S. & Abdel-Salam, A. Three Cladosporium spp. as promising biological control candidates for controlling whiteflies (Bemisia spp.) in Egypt. Pak. J. Biol. Sci. 1, 188–195 (1998).
Abdel-Baky, N. & Abdel-Salam, A. Natural incidence of Cladosporium spp. as a bio-control agent against whiteflies and aphids in Egypt. J. Appl. Entomol. 127, 228 (2003).
Salvatore, M. M., Andolfi, A. & Nicoletti, R. The genus Cladosporium: A rich source of diverse and bioactive natural compounds. Molecules 26, 3959 (2021).
Hamed, M., Osman, A. A. & Ateş, M. Statistical optimization of L-asparaginase production by Cladosporium tenuissimum. Egypt. Pharm. J. 20, 51 (2021).
El-Sabbagh, S. M., Eissa, O. A. E. & Sallam, M. H. E. Taxol production by an endophytic fungus Cladosporium cladosporioides isolated from Catheranthus roseus. Egypt. J. Exp. Biol. 15, 13 (2019).
Vázquez-Montoya, E. L., Castro-Ochoa, L. D., Maldonado-Mendoza, I. E., Luna-Suárez, S. & Castro-Martínez, C. Moringa straw as cellulase production inducer and cellulolytic fungi source. Rev. Argent. Microbiol. 52, 4–12 (2020).
Bastos, S. C. et al. Pectinases from a new strain of Cladosporium cladosporioides (Fres.) De Vries isolated from coffee bean. World J. Agric. Sci. 9, 167–172 (2013).
Al-Bedak, O. A., Abdel-Sater, M. A., Abdel-Latif, A. M. & Abdel-Wahab, D. A. Endophytic mycobiota and enzymatic capacity in wild and cultivated plants in New Valley, Egypt: A comparative analysis. J. Basic Appl. Mycol. (Egypt) 12, 27–41 (2021).
Moharram, A. M., Zohri, A. A., Hesham, A., Maher, M. A. & Al-Bedak, O. A. Production of cocktail enzymes by three Cladosporium isolates and bioconversion of orange peel wastes into valuable enzymes. J. Pure Appl. Microbiol. 15, 2336–2346 (2021).
Grzonka, Z., Kasprzykowski, F. & Wiczk, W. Cysteine Proteases. In: Polaina, J., MacCabe, A.P. (eds) Industrial Enzymes. (Springer, Dordrecht, 2007). https://doi.org/10.1007/1-4020-5377-0_11.
Schäfer, T. et al. Industrial enzymes. White Biotechnol. 105, 59–131 (2006).
Singh, R., Mittal, A., Kumar, M. & Mehta, P. Amylases: A note on current applications. Int. Res. J. Biol. Sci. 5, 27–32 (2016).
Dewan, S. Global Markets for Enzymes in Industrial Applications (BCC Research, 2017).
Sarmiento, F., Peralta, R. & Blamey, J. M. Cold and hot extremozymes: Industrial relevance and current trends. Front. Bioeng. Biotechnol. 3, 148 (2015).
Białkowska, A. & Turkiewicz, M. Cold-Adapted Yeasts 377–395 (Springer, 2014).
Pulicherla, K., Ghosh, M., Kumar, P. & Rao, K. Psychrozymes—The next generation industrial enzymes. J. Mar. Sci. Res. Dev. 1, 2 (2011).
Kumari, M. et al. Biotechnological potential of psychrophilic microorganisms as the source of cold-active enzymes in food processing applications. 3 Biotech 11, 1–18 (2021).
Gerday, C. Psychrophily and catalysis. Biology 2, 719–741 (2013).
Kuddus, M. Cold-active enzymes in food biotechnology: An updated mini review. J. Appl. Biol. Biotechnol. 6, 5 (2018).
Joshi, S. & Satyanarayana, T. (2013).
Santiago, M., Ramírez-Sarmiento, C. A., Zamora, R. A. & Parra, L. P. Discovery, molecular mechanisms, and industrial applications of cold-active enzymes. Front. Microbiol. 7, 1408 (2016).
Al-Ghanayem, A. A. & Joseph, B. Current prospective in using cold-active enzymes as eco-friendly detergent additive. Appl. Microbiol. Biotechnol. 104, 2871–2882 (2020).
Benoit, I. et al. Degradation of different pectins by fungi: Correlations and contrasts between the pectinolytic enzyme sets identified in genomes and the growth on pectins of different origin. BMC Genomics 13, 1–11 (2012).
Adapa, V., Ramya, L., Pulicherla, K. & Rao, K. Cold active pectinases: Advancing the food industry to the next generation. Appl. Biochem. Biotechnol. 172, 2324–2337 (2014).
Willats, W. G., McCartney, L., Mackie, W. & Knox, J. P. Pectin: Cell biology and prospects for functional analysis. Plant Mol. Biol. 47, 9–27 (2001).
Semenova, M. et al. Use of a preparation from fungal pectin lyase in the food industry. Appl. Biochem. Microbiol. 42, 598–602 (2006).
Kashyap, D., Vohra, P., Chopra, S. & Tewari, R. Applications of pectinases in the commercial sector: A review. Bioresour. Technol. 77, 215–227 (2001).
Garg, G. et al. Microbial pectinases: An ecofriendly tool of nature for industries. 3 Biotech 6, 1–13 (2016).
Gummadi, S. N. & Kumar, D. S. Microbial pectic transeliminases. Biotech.nol. Lett. 27, 451–458 (2005).
Carrasco, M., Rozas, J. M., Alcaíno, J., Cifuentes, V. & Baeza, M. Pectinase secreted by psychrotolerant fungi: Identification, molecular characterization and heterologous expression of a cold-active polygalacturonase from Tetracladium sp.. Microb. Cell Fact. 18, 1–11 (2019).
Hebert, P. D., Cywinska, A., Ball, S. L. & Dewaard, J. R. Biological identifications through DNA barcodes. Proc. R. Soc. Lond. Ser. B Biol. Sci. 270, 313–321 (2003).
De Queiroz, K. Species concepts and species delimitation. Syst. Biol. 56, 879–886 (2007).
Verkley, G., Quaedvlieg, W., Shin, H.-D. & Crous, P. A new approach to species delimitation in Septoria. Stud. Mycol. 75, 213–305 (2013).
Woudenberg, J., Groenewald, J., Binder, M. & Crous, P. Alternaria redefined. Stud. Mycol. 75, 171–212 (2013).
Liu, X.-Z. et al. Phylogeny of tremellomycetous yeasts and related dimorphic and filamentous basidiomycetes reconstructed from multiple gene sequence analyses. Stud. Mycol. 81, 1–26 (2015).
Fuhrman, J. A. Microbial community structure and its functional implications. Nature 459, 193–199 (2009).
Garza, D. R., Van Verk, M. C., Huynen, M. A. & Dutilh, B. E. Bottom-up ecology of the human microbiome: from metagenomes to metabolomes. BioRxiv. https://doi.org/10.1101/060673 (2016).
Levy, M., Blacher, E. & Elinav, E. Microbiome, metabolites and host immunity. Curr. Opin. Microbiol. 35, 8–15 (2017).
Bensch, K. et al. Cladosporium species in indoor environments. Stud. Mycol. 89, 177–301 (2018).
Zalar, P. et al. Phylogeny and ecology of the ubiquitous saprobe Cladosporium sphaerospermum, with descriptions of seven new species from hypersaline environments. Stud. Mycol. 58, 157–183 (2007).
Adapa, V., Ramya, L., Pulicherla, K. & Rao, K. S. Cold active pectinases: Advancing the food industry to the next generation. Appl. Biochem. Biotechnol. 172, 2324–2337 (2014).
Pedrolli, D. B., Monteiro, A. C., Gomes, E. & Carmona, E. C. Pectin and pectinases: Production, characterization and industrial application of microbial pectinolytic enzymes. Open Biotechnol. J. 3, 9–18 (2009).
Poveda, G., Gil-Durán, C., Vaca, I., Levicán, G. & Chávez, R. Cold-active pectinolytic activity produced by filamentous fungi associated with Antarctic marine sponges. Biol. Res. 51, 28 (2018).
Ming, X., Huai, Q., Huamei, W., Zhuyan, L. & Jian, Z. On kinetics of batch fermentation for pectinase from mutant of Cladosporium herbarum (pers) link ex gray. Guizhou Sci., 2 (1997).
Bastos, S. C. et al. Microorganisms in Industry and Environment: From Scientific and Industrial Research to Consumer Products 538–542 (World Scientific, 2011).
Bruno, S., Coppola, D., di Prisco, G., Giordano, D. & Verde, C. Enzymes from marine polar regions and their biotechnological applications. Mar. Drugs 17, 544 (2019).
Kumar, A., Mukhia, S. & Kumar, R. Industrial applications of cold-adapted enzymes: Challenges, innovations and future perspective. 3 Biotech 11, 1–18 (2021).
Van Truong, L., Tuyen, H., Helmke, E., Binh, L. T. & Schweder, T. Cloning of two pectate lyase genes from the marine Antarctic bacterium Pseudoalteromonas haloplanktis strain ANT/505 and characterization of the enzymes. Extremophiles 5, 35–44 (2001).
Mangiagalli, M., Brocca, S., Orlando, M. & Lotti, M. The, “cold revolution”. Present and future applications of cold-active enzymes and ice-binding proteins. New Biotechnol. 55, 5–11 (2020).
Jayani, R. S., Saxena, S. & Gupta, R. Microbial pectinolytic enzymes: A review. Process Biochem. 40, 2931–2944 (2005).
Dos Santos, T. C. et al. Prickly palm cactus husk as a raw material for production of ligninolytic enzymes by Aspergillus niger. Food Sci. Biotechnol. 25, 205–211 (2016).
Takasawa, T. et al. Polygalacturonase isolated from the culture of the psychrophilic fungus Sclerotinia borealis. Can. J. Microbiol. 43, 417–424 (1997).
Gadre, R. V., Van Driessche, G., Van Beeumen, J. & Bhat, M. K. Purification, characterisation and mode of action of an endo-polygalacturonase from the psychrophilic fungus Mucor flavus. Enzyme Microb. Technol. 32, 321–330 (2003).
Johnston, D. & Williamson, B. Purification and characterization of four polygalacturonases from Botrytis cinerea. Mycol. Res. 96, 343–349 (1992).
Flannigan, B. Air sampling for fungi in indoor environments. J. Aerosol Sci. 28, 381–392 (1997).
Berry, E. D. & Wells, J. E. A direct plating method for estimating populations of Escherichia coli O157 in bovine manure and manure-based materials. J. Food Prot. 71, 2233–2238 (2008).
Gerlach, W., Nirenberg, H., Eckart, I., Rummland, I. & Schwarz, R. The Genus Fusarium: A Pictorial Atlas Vol. 209 (Kommissionsverlag P. Parey, 1982).
Smith, D. & Onions, A. H. The Preservation and Maintenance of Living Fungi (CAB International, 1994).
Kornerup, A. & Wanscher, J. (1978).
Moubasher, A. H., Ismail, M. A., Al-Bedak, O. A. & Mohamed, R. A. Ramophialophora chlamydospora, a new species from an alkaline lake of Wadi-El-Natron, Egypt. Asian J. Mycol. 2, 110–117 (2019).
White, T. J., Bruns, T., Lee, S. & Taylor, J. Amplification and direct sequencing of fungal ribosomal RNA genes for phylogenetics. PCR Protoc. A Guide Methods Appl. 18, 315–322 (1990).
Carbone, I. & Kohn, L. M. A method for designing primer sets for speciation studies in filamentous ascomycetes. Mycologia 91, 553–556 (1999).
Rehner, S. A. & Samuels, G. J. Taxonomy and phylogeny of Gliocladium analysed from nuclear large subunit ribosomal DNA sequences. Mycol. Res. 98, 625–634 (1994).
Al-Bedak, O. A. & Moubasher, A. H. Aspergillus gaarensis, a new addition to section Circumdati from soil of Lake El-Gaar in Wadi-El-Natron, Egypt. Stud. Fungi 5, 59–65 (2020).
Katoh, K. & Standley, D. M. MAFFT multiple sequence alignment software version 7: Improvements in performance and usability. Mol. Biol. Evol. 30, 772–780 (2013).
Criscuolo, A. & Gribaldo, S. BMGE (block mapping and gathering with entropy): A new software for selection of phylogenetic informative regions from multiple sequence alignments. BMC Evol. Biol. 10, 210 (2010).
Guindon, S. et al. New algorithms and methods to estimate maximum-likelihood phylogenies: Assessing the performance of PhyML 3.0. Syst. Biol. 59, 307–321 (2010).
Felsenstein, J. Confidence limits on phylogenies: An approach using the bootstrap. Evolution 39, 783–791 (1985).
Posada, D. & Crandall, K. A. Modeltest: Testing the model of DNA substitution. Bioinformatics (Oxford) 14, 817–818 (1998).
Kumar, S., Stecher, G., Li, M., Knyaz, C. & Tamura, K. MEGA X: Molecular evolutionary genetics analysis across computing platforms. Mol. Biol. Evol. 35, 1547–1549 (2018).
Hesham, A. New safety and rapid method for extraction of genomic DNA from bacteria and yeast strains suitable for PCR amplifcations. J. Pure Appl. Microbiol. 8, 383–388 (2014).
Miller, G. L. Use of dinitrosalicylic acid reagent for determination of reducing sugar. Anal. Chem. 31, 426–428 (1959).
Lineweaver, H. & Burk, D. The determination of enzyme dissociation constants. J. Am. Chem. Soc. 56, 658–666 (1934).
Tazima, Z. H., Neves, C. S. V. J., Yada, I. F. U. & Júnior, R. P. L. Performance of ‘Okitsu’satsuma mandarin trees on different rootstocks in Northwestern Paraná State. Semina Ciências Agrárias 35, 2297–2308 (2014).
St, L. & Wold, S. Analysis of variance (ANOVA). Chemom. Intell. Lab. Syst. 6, 259–272 (1989).
Funding
Open access funding provided by The Science, Technology & Innovation Funding Authority (STDF) in cooperation with The Egyptian Knowledge Bank (EKB).
Author information
Authors and Affiliations
Contributions
A.M.M., A.-N.A.Z.: Supervision, revising; M.A.M.: Fungal isolation, enzymes production; A.E.H.: Editing, revising; O.A.A.-B.: Molecular work, data analysis, writing, revising; O.A.A.-B., M.A.M.: Enzyme purification and characterization; H.E.F.A.-R., M.A.M.: Enzyme application. All authors have read and agreed to the published version of the manuscript.
Corresponding authors
Ethics declarations
Competing interests
The authors declare no competing interests.
Additional information
Publisher's note
Springer Nature remains neutral with regard to jurisdictional claims in published maps and institutional affiliations.
The original online version of this Article was revised: The original version of this Article contained errors. Modifications have been made to Table 2, Table 4, the Materials and Methods section and in the Data availability section. Full information regarding the corrections made can be found in the correction for this Article.
Rights and permissions
Open Access This article is licensed under a Creative Commons Attribution 4.0 International License, which permits use, sharing, adaptation, distribution and reproduction in any medium or format, as long as you give appropriate credit to the original author(s) and the source, provide a link to the Creative Commons licence, and indicate if changes were made. The images or other third party material in this article are included in the article's Creative Commons licence, unless indicated otherwise in a credit line to the material. If material is not included in the article's Creative Commons licence and your intended use is not permitted by statutory regulation or exceeds the permitted use, you will need to obtain permission directly from the copyright holder. To view a copy of this licence, visit http://creativecommons.org/licenses/by/4.0/.
About this article
Cite this article
Moharram, A.M., Zohri, AN.A., Hesham, A.EL. et al. Production of cold-active pectinases by three novel Cladosporium species isolated from Egypt and application of the most active enzyme. Sci Rep 12, 15599 (2022). https://doi.org/10.1038/s41598-022-19807-z
Received:
Accepted:
Published:
DOI: https://doi.org/10.1038/s41598-022-19807-z
- Springer Nature Limited